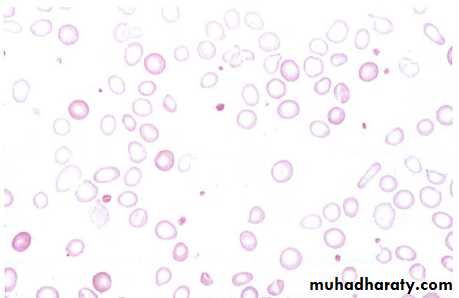

IDA “2”
ObjectivesTo identify symptoms and signs of IDA
To understand biochemical & blood changes in IDATo know the treatment of IDA
To understand pathogenesis & treatment of ACD
To define sideroblastic anemia.
SYMPTOMS OF IDA
• Non-specific symptoms: fatigue, weakness, dyspoea, symptoms of CHF.• Signs: pallor, tachycardia, splenomegaly (minority of patients).
Tissues effects of chronic IDA
• Oral lesions:• Angular cheilosis
• Atrophy of tongue papillae with intermittent glossitis & stomatitis.
• 2. Dysphagia: post-cricoid esophageal webbing (Plummer Vinson syndrome).
3. Nail lesions: (Koilonychia), flattening, thinning, lead to brittle, spoon shape nails. Koilonychia is relatively non-specific finding, it can also result from prolonged exposure to hot soapsuds & other caustic agents.
4. Pica: compulsive ingestion of non-nutritive substances.
Children :craving for & ingestion of clay, dirt, paint.
Adult: to eat ice (pagophagia), clay.
5. In infants: malabsorption, impaired mental function.
6. Premature labor.Epithelial Lesions Associated with Iron Deficiency
Diagnosis
Laboratory studies• Peripheral blood:
• RBC indices:
• MCV (< 76 fl)
• MCH (25-30 gm/L)
• RDW > 16 %
• 2. Peripheral blood smears
• Microcytic hypochromic
• Poikilocytosis = abnormally shaped RBC
• Anisocytosis = vary sized RBC
3. Blood count:
Normal or low reticulocytesOccasionally high pletelets
• Serum iron studies:
• Low s. iron (take early morning sample, withhold iron for at least 24 hrs)
• TIBC increased
• Transferrin saturation < 15 %
• S. ferritin < 12 ng/ml, low normal level does not exclude IDA.
• Serum soluble transferrin saturation receptors increase.
Plasma ferritin is a measure of iron stores in tissues and is the best single test to confirm iron deficiency . It is a very specific test; a subnormal level is due to iron deficiency or, very rarely, hypothyroidism or vitamin C deficiency.
Ferritin levels can be raised in liver disease and in the acute phase response; in these conditions, a ferritin level of up to 100 μg/L may still be compatible with low bone marrow iron stores.
C. BM studies : absence of iron in macrophages when the sample is subjected to Perls stain (Prussian blue stain).
Treatment
• Determine the cause :• Stool for occult blood from GIT bleeding
• Upper & lower GIT endoscope
• Urine analysis
• CXR (for pulmonary hemosiderosis)
• pelvic examination & imaging in females.
• 2. Treat the underlying cause.
3. Iron replacement therapy:
• Oral iron therapyB. Parenteral:
• Iron dextran (imferon): intrmuscular or IV injection. It may lead to hypersensitivity reaction & anaphylacsis to the dextran & permanent stain with discoloration at injection site. The latter can be avoided by using Z technique of im injection.
2. Iron sucrose(venofar) : safest & no need for test dose. Given iv
3. Ferric gluconate : given imIndication of parenteral iron
• Those who can not tolerate oral iron.• Inflammatory bowel disease & peptic ulcer.
• Does not comply with prescribed dose
• Malabsorption.
• Those suffer from conditions with rapid blood loss & can not compensate with oral dose like HHT (hereditary hemorrhagic telengectasia).
C. Transfusion of whole blood or packed RBC usually not indicated unless rapid increase in Hb is critical to patient.
The treatment should be extended to beyond the point where the anemia is corrected for a period of usually 6 mo in order to replenish depleted iron stores.
Failure to respond to iron therapy should suggest the following:
• Incorrect diagnosis• Continued blood loss
• 3. Presence of chronic infection or inflammation will suppress BM activity.
• 4. Lack of patient compliance
• 5. Malabsorption
Response to iron
• Symptomatic improvement may occur before anemia improvement.
• Pica relieved within 1 wk
• Retic increased early, max. d5-10
• Hb reach normal level by 2 mo
• Oral lesion improve 1-2 wk after Rx up to 2 mo
• Koilonychia need 3-6 mo to improve
Prophylactic iron?
• Infants.• Pregnancy
• Menorrhagia
• Regular blood donars
• Patient using high dose aspirin.
Anaemia of chronic disorders
1 Normochromic, normocytic or mildly hypochromic (MCV rarely <75 fL) indices and red cell morphology.2 Mild and non-progressive anaemia (haemoglobin
rarely <9.0 g/dL)-the severity being related to the severity of the disease.
3 Both the serum iron and TIBC are reduced; sTfR levels are normal.
4 The serum ferritin is normal or raised.
5 Bone marrow storage (reticuloendothelial) iron is
normal
The pathogenesis of this anaemia appears to be related to decreased release of iron from macrophages to plasma, reduced red cell lifespan and an inadequate erythropoietin response to anaemia caused by the effects of cytokines such as IL-1 and tumour necrosis factor (TNF) on erythropoiesis
Hepcidin, released by the liver in response to inflammation, inhibits macrophage release of iron as well as iron absorption.
The anaemia is corrected by successful treatment of the underlying disease and does not respond to iron therapy. Recombinant erythropoietin improves the anaemia in some cases.
causes of a hypochromic, microcytic anaemia.
Sideroblastic anaemia
It is defined by the presence of many pathological ring sideroblasts in the bone marrowThese are abnormal erythroblasts containing numerous iron granules arranged in a ring or collar around the nucleus (>15%)
CAUSES: hereditary, acquired (myelodysplasia, drugs like INH, BM malignant diseases, hemolytic anemia. Alcohol, megaloblastic anemia.
B6 may benefit hereditary SA.